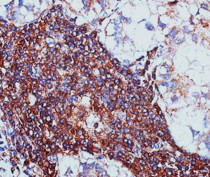

ARG41740
anti-G3BP1 antibody
anti-G3BP1 antibody for ICC/IF,IHC-Formalin-fixed paraffin-embedded sections,Western blot and Human,Mouse,Rat
Overview
| Product Description | Rabbit Polyclonal antibody recognizes G3BP1 |
|---|---|
| Tested Reactivity | Hu, Ms, Rat |
| Tested Application | ICC/IF, IHC-P, WB |
| Host | Rabbit |
| Clonality | Polyclonal |
| Isotype | IgG |
| Target Name | G3BP1 |
| Antigen Species | Human |
| Immunogen | Recombinant fusion protein corresponding to aa. 131-330 of Human G3BP1 (NP_938405.1). |
| Conjugation | Un-conjugated |
| Alternate Names | G3BP; hDH VIII; G3BP-1; GAP SH3 domain-binding protein 1; EC 3.6.4.13; EC 3.6.4.12; HDH-VIII; ATP-dependent DNA helicase VIII; Ras GTPase-activating protein-binding protein 1 |
Application Instructions
| Application Suggestion |
|
||||||||
|---|---|---|---|---|---|---|---|---|---|
| Application Note | * The dilutions indicate recommended starting dilutions and the optimal dilutions or concentrations should be determined by the scientist. | ||||||||
| Positive Control | A431 | ||||||||
| Observed Size | ~ 68 kDa |
Properties
| Form | Liquid |
|---|---|
| Purification | Affinity purified. |
| Buffer | PBS (pH 7.3), 0.02% Sodium azide and 50% Glycerol. |
| Preservative | 0.02% Sodium azide |
| Stabilizer | 50% Glycerol |
| Storage Instruction | For continuous use, store undiluted antibody at 2-8°C for up to a week. For long-term storage, aliquot and store at -20°C. Storage in frost free freezers is not recommended. Avoid repeated freeze/thaw cycles. Suggest spin the vial prior to opening. The antibody solution should be gently mixed before use. |
| Note | For laboratory research only, not for drug, diagnostic or other use. |
Bioinformation
| Database Links |
Swiss-port # P97855 Mouse Ras GTPase-activating protein-binding protein 1 Swiss-port # Q13283 Human Ras GTPase-activating protein-binding protein 1 |
|---|---|
| Gene Symbol | G3BP1 |
| Gene Full Name | GTPase activating protein (SH3 domain) binding protein 1 |
| Background | This gene encodes one of the DNA-unwinding enzymes which prefers partially unwound 3'-tailed substrates and can also unwind partial RNA/DNA and RNA/RNA duplexes in an ATP-dependent fashion. This enzyme is a member of the heterogeneous nuclear RNA-binding proteins and is also an element of the Ras signal transduction pathway. It binds specifically to the Ras-GTPase-activating protein by associating with its SH3 domain. Several alternatively spliced transcript variants of this gene have been described, but the full-length nature of some of these variants has not been determined. [provided by RefSeq, Jul 2008] |
| Function | May be a regulated effector of stress granule assembly. Phosphorylation-dependent sequence-specific endoribonuclease in vitro. Cleaves exclusively between cytosine and adenine and cleaves MYC mRNA preferentially at the 3'-UTR. ATP- and magnesium-dependent helicase. Unwinds preferentially partial DNA and RNA duplexes having a 17 bp annealed portion and either a hanging 3' tail or hanging tails at both 5'- and 3'-ends. Unwinds DNA/DNA, RNA/DNA, and RNA/RNA substrates with comparable efficiency. Acts unidirectionally by moving in the 5' to 3' direction along the bound single-stranded DNA. [UniProt] |
| Cellular Localization | Cytoplasm, cytosol. Cytoplasm, Stress granule. Cell membrane. Nucleus. Note=Cytoplasmic in proliferating cells, can be recruited to the plasma membrane in exponentially growing cells. Cytosolic and partially nuclear in resting cells (By similarity). The unphosphorylated form is recruited to stress granules. HRAS signaling contributes to this process by regulating G3BP dephosphorylation (PubMed:12642610). [UniProt] |
| Calculated MW | 52 kDa |
| PTM | Phosphorylated exclusively on serine residues. Hyperphosphorylated in quiescent fibroblasts. Hypophosphorylation leads to a decrease in endoribonuclease activity (By similarity). RASA1-dependent phosphorylation of Ser-149 induces a conformational change that prevents self-association. Dephosphorylation after HRAS activation is required for stress granule assembly. Ser-149 phosphorylation induces partial nuclear localization. Arg-435 is dimethylated, probably to asymmetric dimethylarginine. [UniProt] |
Images (2) Click the Picture to Zoom In
-
ARG41740 anti-G3BP1 antibody IHC-P image
Immunohistochemistry: Paraffin-embedded Human liver cancer tissue stained with ARG41740 anti-G3BP1 antibody at 1:100 dilution.
-
ARG41740 anti-G3BP1 antibody WB image
Western blot: 25 µg of A431 cell lysate stained with ARG41740 anti-G3BP1 antibody at 1:1000 dilution.